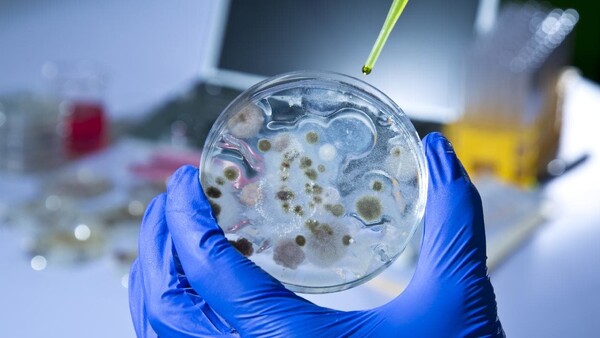

Η θνησιμότητα που συνδέεται με τον καρκίνο μειώθηκε κατά 27% μέσα στα τελευταία 25 χρόνια, σύμφωνα με έκθεση της Αμερικανικής Αντικαρκινικής Εταιρείας, ωστόσο εξακολουθούν να καταγράφονται σημαντικές αποκλίσεις του δείκτη ανάμεσα στους πλούσιους και τους φτωχούς καρκινοπαθείς.
Στις ΗΠΑ, ο αγώνας εναντίον του καρκίνου μοιάζει να φέρνει καρπούς. Η θνησιμότητα που οφείλεται στον καρκίνο μειώνεται με σταθερό ρυθμό εδώ και πάνω από ένα τέταρτο του αιώνα, όπως κατέγραψε έρευνα της Αμερικανικής Αντικαρκινικής Εταιρείας που δόθηκαν στη δημοσιότητα την Τρίτη.
Βεβαίως, εάν συγκριθεί με το σύνολο του 20ού αιώνα, ο συνολικός αριθμός των θανάτων καταγράφει άνοδο. Αλλά από την κορύφωσή του, το 1991, όταν ο δείκτης ανερχόταν σε 215,1 θανάτους ανά 100.000 κατοίκους, ο δείκτης θνησιμότητας μειώνεται σταθερά κατά 1,5% τον χρόνο, και υποχώρησε τους 156 θανάτους ανά 100.000 κατοίκους το 2016.
Η υποχώρηση αυτή οφείλεται κυρίως στις «προσπάθειες που έγιναν για πολύ καιρό προκειμένου να μειωθούν οι καπνιστές και στις προόδους που έχουν γίνει στη διάγνωση και τη θεραπεία του καρκίνου στα πιο πρώιμα στάδια», επισημαίνει η αμερικανική εφημερίδα The Wall Street Journal.
Αυτό μεταφράζεται σε περίπου 2,6 εκατομμύρια λιγότερους θανάτους από καρκίνο σε σύγκριση με τον αριθμό που θα καταγραφόταν εάν το ποσοστό θνησιμότητας παρέμενε στο επίπεδο του 1991, εξηγούν οι ερευνητές.
Η τάση είναι πολύ καλή είδηση -ο καρκίνος είναι μια από τις βασικές αιτίες θανάτου στις ΗΠΑ, μαζί με τις καρδιαγγειακές παθήσεις και τα δυστυχήματα, κατά τα πιο πρόσφατα επίσημα στοιχεία.
Αλλά παρ' όλες τις προσπάθειες που έχουν καταβληθεί, ο δείκτης θνησιμότητας του καρκίνου δεν έχει πέσει στο μηδέν. Οι ερευνητές προβλέπουν 1,7 εκατ. νέα κρούσματα και 600.000 θανάτους από καρκίνο στις το 2019.
Σύμφωνα με την έκθεση, οι άνδρες πεθαίνουν συχνότερα από καρκίνο του πνεύμονα, του προστάτη ή στο κόλον, ενώ οι γυναίκες από καρκίνο του πνεύμονα, του μαστού και του παχέος εντέρου. Αυτές ακριβώς είναι επίσης οι συχνότερες μορφές καρκίνου στη Γαλλία.
Οι φυλετικές, εθνικές και κοινωνικές ομάδες παρουσιάζουν επίσης αποκλίσεις ως προς τους δείκτες θνησιμότητας από τον καρκίνο.
Οι άνθρωποι που ζουν στις φτωχότερες κομητείες των ΗΠΑ έχουν πολύ υψηλότερες πιθανότητες να καπνίζουν και να είναι παχύσαρκοι.
Την περίοδο 2012-2016, ο δείκτης θνησιμότητας στις φτωχότερες περιοχές ήταν 2 φορές υψηλότερος σε περιπτώσεις καρκίνου του τραχήλου της μήτρας στις γυναίκες και 40% υψηλότερος σε κρούσματα καρκίνου του πνεύμονα και του ήπατος στις φτωχότερες κομητείες σε σύγκριση με αυτές που κατέγραφαν μεγαλύτερα εισοδήματα.
Η φτώχεια συνδέεται επίσης με πολύ χαμηλότερα επίπεδα συχνών ιατρικών εξετάσεων, πράγμα που συχνά οδηγεί στον εντοπισμό της ασθένειας σε αργότερο στάδιο, ενώ συνεπάγεται επίσης ότι υπάρχουν λιγότερες πιθανότητες να προσφερθεί στον ασθενή η καλύτερη -που τις περισσότερες φορές είναι επίσης ακριβότερη- θεραπεία.
Με πληροφορίες από ΑΠΕ-ΜΠΕ